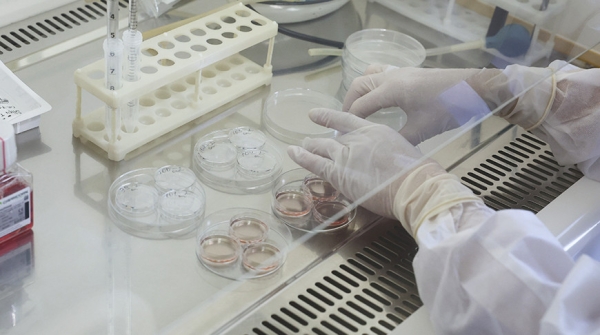
Первый человек в мире умер от птичьего гриппа H5N5

Первый человек в мире умер от птичьего гриппа H5N5
Опубликовано:

В мире 22 ноября 2025, 23:29 Первый человек в мире умер от птичьего гриппа H5N5

Фото из архива 22 ноября, Минск /Корр. БЕЛТА/. В американском штате Вашингтон умер первый пациент, заразившийся штаммом птичьего гриппа H5N5, который ранее не встречался у людей. Об этом сообщает Euronews.
Департамент здравоохранения штата сообщил, что умерший был в преклонном возрасте, а также имел серьезные проблемы со здоровьем. По информации властей, на заднем дворе дома пациента было обнаружено небольшое стадо домашней птицы разных видов.
На сегодняшний день все примерно 70 случаев заболевания людей в Соединенных Штатах за последние полтора года были связаны со штаммом H5N1. Однако недавняя смерть в Вашингтоне стала новой вехой: вирус H5N5, который ранее фиксировался исключительно у животных, впервые был выявлен у человека.
Тем не менее, как заверили представители органов здравоохранения, угроза для населения невелика. Было заявлено, что ни у одного человека, контактировавшего с пациентом, не было обнаружено положительных результатов, и нет никаких доказательств передачи вируса от человека к человеку.-0-
Источник: www.belta.by